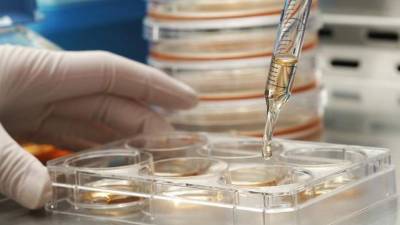
Realizan estudios para crear células hibridas.

Estados Unidos
Unos genes que se cree que aumentan el riesgo de autismo podrían también estar asociados con una inteligencia más alta, sugiere un estudio reciente.
Los investigadores analizaron el ADN de casi 10,000 personas en Escocia, y también evaluaron sus capacidades de pensamiento. En promedio, los que portaban genes asociados con el autismo puntuaron ligeramente más alto en las pruebas de pensamiento (cognitivas).
Tener genes vinculados con el autismo no significa que las personas contraerán el trastorno, anotaron los investigadores.
Se encontraron evidencias similares de una asociación entre los genes vinculados con el autismo y la inteligencia en unas pruebas anteriores de 921 adolescentes australianos, según el estudio, que aparece en la edición del 10 de marzo de la revista Molecular Psychiatry.
'Nuestros hallazgos muestran que la variación genética que aumenta el riesgo de autismo se asocia con una mejor capacidad cognitiva en los individuos no autistas', apuntó la líder del estudio, Toni-Kim Clarke, de la Universidad de Edimburgo, en Escocia.
'A medida que comenzamos a comprender la forma en que las variantes genéticas asociadas con el autismo impactan a la función cerebral, quizá podamos comprender más la naturaleza de la inteligencia autista', planteó Clarke en un comunicado de prensa de la universidad.
Otro investigador fue más lejos. 'Este estudio sugiere que los genes del autismo podrían en realidad otorgar, en promedio, una pequeña ventaja intelectual a los portadores, siempre y cuando no les afecte el autismo', planteó en el comunicado de prensa Nick Martin, director del Laboratorio de Epidemiología Genética del Instituto de Investigación Médica de Queensland, en Australia.
Aunque el 70% de las personas con autismo tienen discapacidades intelectuales, algunas personas con el trastorno tienen una inteligencia no verbal superior al promedio, anotaron los autores del estudio.
El estudio solo reveló una asociación, y no un vínculo causal, entre los genes relacionados con el autismo y la inteligencia.
Unos genes que se cree que aumentan el riesgo de autismo podrían también estar asociados con una inteligencia más alta, sugiere un estudio reciente.
Los investigadores analizaron el ADN de casi 10,000 personas en Escocia, y también evaluaron sus capacidades de pensamiento. En promedio, los que portaban genes asociados con el autismo puntuaron ligeramente más alto en las pruebas de pensamiento (cognitivas).
Tener genes vinculados con el autismo no significa que las personas contraerán el trastorno, anotaron los investigadores.
Se encontraron evidencias similares de una asociación entre los genes vinculados con el autismo y la inteligencia en unas pruebas anteriores de 921 adolescentes australianos, según el estudio, que aparece en la edición del 10 de marzo de la revista Molecular Psychiatry.
'Nuestros hallazgos muestran que la variación genética que aumenta el riesgo de autismo se asocia con una mejor capacidad cognitiva en los individuos no autistas', apuntó la líder del estudio, Toni-Kim Clarke, de la Universidad de Edimburgo, en Escocia.
'A medida que comenzamos a comprender la forma en que las variantes genéticas asociadas con el autismo impactan a la función cerebral, quizá podamos comprender más la naturaleza de la inteligencia autista', planteó Clarke en un comunicado de prensa de la universidad.
Otro investigador fue más lejos. 'Este estudio sugiere que los genes del autismo podrían en realidad otorgar, en promedio, una pequeña ventaja intelectual a los portadores, siempre y cuando no les afecte el autismo', planteó en el comunicado de prensa Nick Martin, director del Laboratorio de Epidemiología Genética del Instituto de Investigación Médica de Queensland, en Australia.
Aunque el 70% de las personas con autismo tienen discapacidades intelectuales, algunas personas con el trastorno tienen una inteligencia no verbal superior al promedio, anotaron los autores del estudio.
El estudio solo reveló una asociación, y no un vínculo causal, entre los genes relacionados con el autismo y la inteligencia.